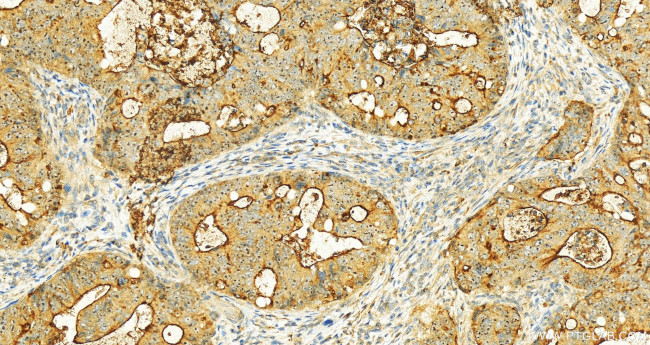
MUC13 Antibody in Immunohistochemistry (Paraffin) (IHC (P))

Search
Proteintech
MUC13 Polyclonal Antibody
{{$productOrderCtrl.translations['antibody.pdp.commerceCard.promotion.promotions']}}
{{$productOrderCtrl.translations['antibody.pdp.commerceCard.promotion.viewpromo']}}
{{$productOrderCtrl.translations['antibody.pdp.commerceCard.promotion.promocode']}}: {{promo.promoCode}} {{promo.promoTitle}} {{promo.promoDescription}}. {{$productOrderCtrl.translations['antibody.pdp.commerceCard.promotion.learnmore']}}
产品信息
55487-1-AP
种属反应
宿主/亚型
分类
类型
抗原
偶联物
形式
浓度
规格
纯化类型
保存液
内含物
保存条件
运输条件
靶标信息
Mucin 13, epithelial transmembrane. SEA is an extracellular domain associated with O-glycosylation. Proteins found to contain SEA-modules include, agrin, enterokinase, 63 kDa sea urchin (Strongylocentrotus purpuratus) sperm protein, perlecan (heparan sulphate proteoglycan core, mucin 1 and the cell surface antigen, 114/A10, and two functionally uncharacterised, probably extracellular, Caenorhabditis elegans proteins. Despite the functional diversity of these adhesive proteins, a common denominator seems to be their existence in heavily glycosylated environments. In addition, the better characterised proteins all contain O-glycosidic-linked carbohydrates such as heparan sulphate that contribute considerably to their molecular masses. The common module might regulate or assist binding to neighbouring carbohydrate moieties. Enterokinase, the initiator of intestinal digestion, is a mosaic protease composed of a distinctive assortment of domains.
仅用于科研。不用于诊断过程。未经明确授权不得转售。
篇参考文献 (0)
生物信息学
蛋白别名: Down-regulated in colon cancer 1; MUC-13; mucin 13; mucin 13, epithelial transmembrane; Mucin-13; unnamed protein product
基因别名: DRCC1; MUC-13; MUC13; RECC; UNQ6194/PRO20221
UniProt ID: (Human) Q9H3R2
Entrez Gene ID: (Human) 56667